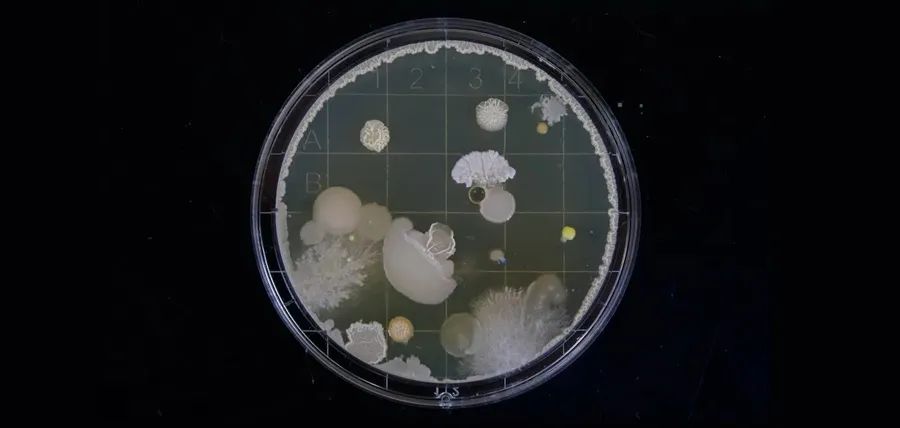
忘洗蛋*粉白**杯，臭得令人窒息！还有救？

本文适合所有健身爱好者
内容标签:疯狂热量 力量增长 借鉴 杜绝
原著:Pete Schenkel
有一天,你忘了清理你的摇摇杯。
过了很久,你打开它,你很难忘了那种可怕的气味——如果你喝过蛋*粉白**,你就知道我在说什么。
蛋*粉白**是个好东西,但为什么冲个蛋*粉白**杯子会变成这种味?!
摇摇杯之所以会产生难闻的气味,是因为细菌和霉菌在摇摇杯中滋生,这跟大多数摇摇杯使用的塑料类型有关,这些塑料成分导致细菌扎根在瓶子里,难以除味。
蛋*粉白**本身并没有什么味道,它也不会随着时间的推移而变质、失去营养价值、发霉。然而,一旦和水混在一起,它就会变成一个细菌和霉菌滋生的环境,当你喝完把杯子扔一边忘记洗之后。就跟忘记洗脏盘子道理一样,它们最终会变得十分恶心。
用过的摇摇杯被遗忘的可能性有多大?根据我的经验,它们有可能出现在这些地方。
l 健身房的储物柜里
l 你的健身包里
l 厨房洗脏盘子的水池里
温暖的、封闭的空间更有助于微生物的生长。除了杯子很容易忘记洗之外,杯子本身的塑料成分是那种腐败气味背后的第二个原因。
相比起其他材质的杯子,塑料也更不容易清洗干净。

并且现在很多蛋*粉白**摇杯,结构复杂(例如杯盖、杯子的底部有死角),更容易造成藏污纳垢。

摇摇杯是由哪种塑料制成的?
一般来说,摇蛋*粉白**的杯子是由坚硬的热塑性塑料制成的,例如:
l 高密度聚乙烯(HDPE)
l 聚丙烯(PP)
从本质上讲,这些种类的塑料是由长的分子链(称为聚合物)组成的。
这些分子链相互叠加,构成了塑料的基础。
较大的分子,如水,不能通过这些链;较小的分子,如细菌,可以附着在摇摇杯的杯壁上,并卡在那里,使它们难以清除。
虽然这些细菌分子最终会自行消散,但这些气味,可能会一直存在。
用有味的摇摇杯喝粉会让人生病吗?
是的,病从口入,你会因为发臭的摇摇杯而生病的。
这几乎是跟轻度的食物中毒原理差不多了,杯子发臭后不要偷懒,赶紧去清理。
如果你已经试了很多法子洗杯子,但杯子还是有味道,也许最好的法子是直接把它扔掉,然后买一个新的。
至少因此忍受臭味甚至生病是不值得的。

喝完蛋*粉白**的杯子不臭,说明是假粉?
完全没有道理!
正如上文所说:1、造成臭杯的主要原因是细菌,即便没有冲粉只是喝水,也会因细菌滋生而臭杯。
2、喝完一杯蛋*粉白**,剩下的蛋白质只能以“毫克”计算,用“毫克”的蛋白质残留来评估真假粉,毫无依据。
3、大部分假粉,多半是氨基酸或者肽造假,并不会比蛋*粉白**更清洁。
4、何况,目前很多蛋*粉白**都添加了较多的人工香料,稳定性极强,会冲淡气味。

如何预防摇摇杯发出臭味?
有几件事你可以做,以确保摇摇杯不会臭到完全不能用的地步:
1. 买一个不锈钢的蛋*粉白**摇摇杯,如前所述,大多数摇摇杯会变得很恶心很难闻,是因为它们是由塑料制成的,而不锈钢更容易清洗,细菌也不容易附着在杯壁上。

2. 水分是导致细菌生长的主要原因,所以蛋*粉白**要“现喝现摇“,不要摇完放在那等很久再喝。你要确保杯子平时总是干燥的,只有在喝蛋白质的时候杯子里才出现水。
3. 饮用完毕后,尽快清理干净。即使没时间或者精力认真洗,只用清水冲一冲也非常有助于防止细菌和气味的产生。

4.最好的方法:多准备几个杯子,不爽就换一个。
但如果你的杯子已经臭了怎么办?
这里有几个选择:
l 用洗碗机洗:如果你的杯子脏得离谱,可能需要机洗两三次,但这是最简单的选择了,只需要一点洗洁精,那种难闻的气味就几乎最小化了。
l 如果你没有洗碗机,你可以用高温+洗洁精把它浸泡十五分钟,再刷洗。
l 这还不够的话,再试试小苏打,和水混合之后,放置大约一个小时,然后用洗洁精洗掉。

l 假牙清洁片也可能有用,热水,浸泡15分钟,冲洗。
l 或者用沸水和大约1-2匙醋浸泡几个小时。
l 不管你用什么浸泡,最后的步骤都是钢丝球和一些手臂劳动。光选对了清洁剂,擦不干净也不行。因为你不能把残余的清洁剂吞进肚子里。
总结
摇摇杯气味如此难闻的原因是:蛋*粉白**和水混合会使杯子变成细菌生长繁殖的主要场所,而且这些气味会根植于塑料中,可能让你生病。
预防是最简单的,冲完粉马上喝,不要等等再喝。
喝之后立即清洗它,不要等等再洗。
如果它已经很难闻了,那么你可以试着使用各种东西清洁,包括醋、假牙清洁片和小苏打。